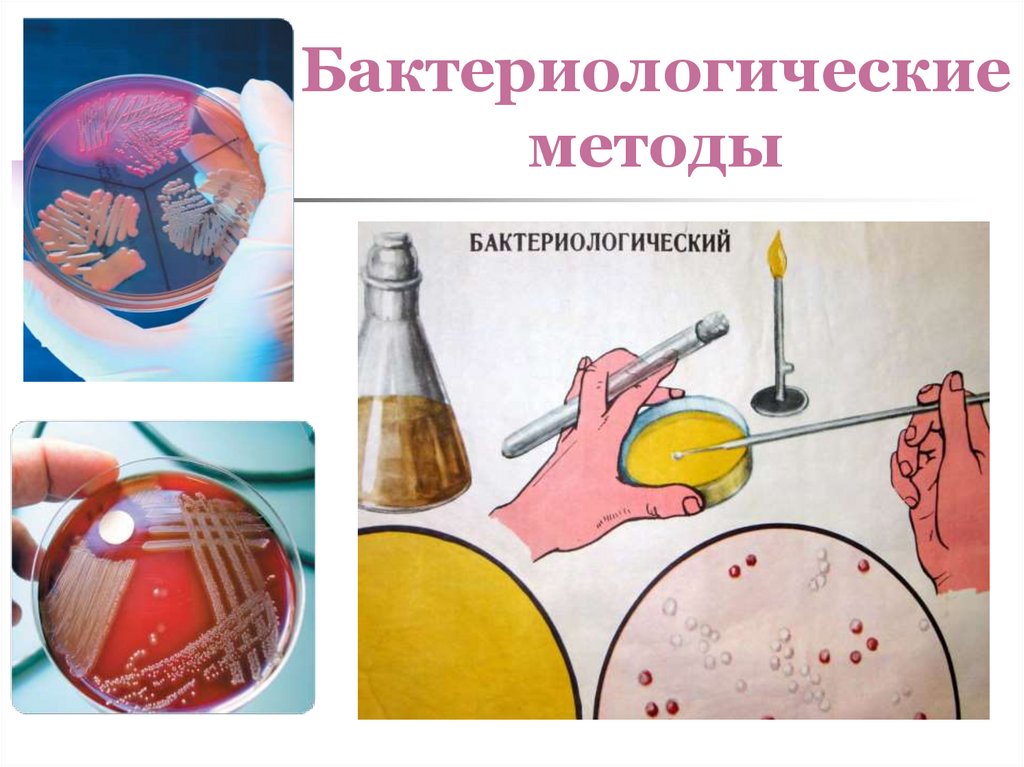
Бактериологические методы

Similar presentations:
Введение в проблему инфекционных болезней
1. Введение в проблему инфекционных болезней
Орлова Светлана Николаевна,доктор медицинских наук, профессор
зав. кафедрой инфекционных болезней,
эпидемиологии и дерматовенерологиии
2.
Кафедраинфекционных болезней,
эпидемиологии
и дерматовенерологии
3. Кафедра инфекционных болезней
Областное бюджетное учреждениездравоохранения
«1-ая городская клиническая больница города
Иванова»
2 корпус,
1-й этаж
Вход напротив хирургического приемного
отделения
4. Кафедра инфекционных болезней
Первые сведения о кафедре инфекционныхболезней относятся к 1937 году, в это время
заведующим кафедрой был
Петр Вениаминович Сквирский –
профессор, доктор медицинских наук,
получивший образование в Берлинском
университете на медицинском факультете,
который окончил в 1910 году.
В 1939 году на кафедру приходит аспирант
Елизавета Петровна Ужинова.
5. Кафедра инфекционных болезней
Аспирантура Е.П. Ужиновой былапрервана Великой отечественной
войной, с августа 1941 года по
октябрь 1945 года – она начальник
медицинского отделения армейского
полевого подвижного госпиталя
№ 3826, с которым Елизавета
Петровна прошла путь от Москвы до
Бухареста.
С ноября 1945 года – ассистент
кафедры инфекционных болезней.
6. Кафедра инфекционных болезней
1949 год – защитакандидатской диссертации,
1951 год – доцент кафедры
инфекционных болезней,
1957 год – защита докторской
диссертации.
С 1953 г. по 1986 г.
Е.П. Ужинова была
заведующей кафедрой
инфекционных болезней
ИГМИ.
7. Елизавета Петровна Ужинова
Доктор медицинских наукПрофессор
Заслуженный деятель науки РФ
Майор медицинской службы
Кавалер орденов Красной Звезды,
Отечественной войны I-II степени
Проректор по учебной работе ИГМИ
Почетный гражданин города Иванова
Отличник здравоохранения
Е.П. Ужиновой написано 230 научных
работ, под её руководством
выполнены и защищены
1 докторская и 17 кандидатских
диссертаций
Премия им. Е.П. Ужиновой женщинам
города Иванова
8. Кафедра инфекционных болезней
С 1988 по 2007 годызаведующим кафедрой
инфекционных болезней,
эпидемиологии и военной
эпидемиологии был
Чернобровый Виталий Федорович
кандидат медицинских наук, профессор,
Заслуженный врач России
Участник ликвидации аварии
на Чернобыльской АЭС
9. Кафедра инфекционных болезней
Заведующая кафедрой –Орлова Светлана Николаевна
доктор медицинских наук,
профессор,
врач высшей категории
Область научных интересов:
стенозирующие ларинготрахеиты,
герпетическая инфекция,
дисбактериоз кишечника,
лечение больных хроническими
гепатитами С, В
10. Кафедра инфекционных болезней
Доцент кафедры –Шибачева Нина Николаевна
кандидат медицинских наук,
врач высшей категории,
эпидемиолог ОБУЗ «1-я ГКБ»
г. Иванова
Область научных интересов:
кишечные инфекции,
гельминтозы,
герпетическая инфекция,
иммунопрофилактика,
внутрибольничные инфекции
11. Кафедра инфекционных болезней
Доцент кафедры –Федосеева Елена Сергеевна
кандидат медицинских наук,
врач высшей категории,
декан факультета иностранных
студентов
Область научных интересов:
природно-очаговые инфекции,
малярия,
гельминтозы, в том числе
жарких стран
12. Кафедра инфекционных болезней
Доцент кафедры –Копышева Елена Николаевна,
кандидат медицинских наук
врач высшей категории
Область научных интересов:
респираторные инфекции,
герпетическая инфекция,
иммунопрофилактика,
экзантемные инфекции
13. Кафедра инфекционных болезней
Доцент кафедры –Машин Сергей Александрович
кандидат медицинских наук
Область научных интересов:
респираторные вирусные
инфекции,
инфекционный мононуклеоз,
ВИЧ-инфекция
14. Кафедра инфекционных болезней
Доцент кафедры –Калистратова Елена Петровна
кандидат медицинских наук
врач высшей категории
Область научных интересов:
Респираторные вирусные
инфекции, стенозирующие
ларинготрахеиты,
дисбактериозы кишечника
15. Кафедра инфекционных болезней
Доцент кафедры –Дудник Оксана Валентиновна
кандидат медицинских наук
Область научных интересов:
Вирусные гепатиты,
противовирусное лечение,
природно-очаговые
инфекции
16. Кафедра инфекционных болезней
Ассистент кафедры –Лебедев Сергей Евгеньевич
врач высшей категории
Область научных интересов:
кишечные инфекции,
гельминтозы,
вирусные гепатиты
у ВИЧ-инфицированных
пациентов
17. Кафедра инфекционных болезней
Ассистент кафедры –Федотова Наталья Николаевна
осуществляющая научное
исследование по проблеме
острых кишечных инфекций,
роди дисбиоза кишечника
в формировании тяжелых
форм ОКИ
18. Кафедра инфекционных болезней
Ассистент кафедры –Колосова Мария Александровна
осуществляющая научное
исследование по проблеме
вирусных инфекций,
передающихся
воздушно-капельным путем
19. Кафедра инфекционных болезней
За время обучения на кафедре студенты изучают:20. Кафедра инфекционных болезней
Лучшим способомпрофилактики
инфекционных болезней
является вакцинация!
21. Кафедра инфекционных болезней
За время обучения на кафедре студенты изучают:22. Кафедра инфекционных болезней
За время обучения на кафедре студенты изучают:23. Кафедра инфекционных болезней
За время обучения на кафедре студенты изучают:24. Кафедра инфекционных болезней
За время обучения на кафедре студенты изучают:25. Кафедра инфекционных болезней
За время обучения на кафедре студенты изучают:26. Почему на Руси грибы всегда «шли под водочку?»
27. Профилактика ботулизма
28. Почему в Японии к суши подают васаби?
29.
Дирофиляриоз:30.
Лихорадка Денге у туристов31.
Геморрагическая лихорадка с почечным синдромом32.
33.
Географическое распределение вспышек болезни Эбола34. Болезнь, вызванная вирусом Зика
Заражение вирусом происходит на разных срокахбеременности, а микроцефалия у всех одинаковая …
35. Болезнь, вызванная вирусом Зика
На сегодняшний день власти США официальнопризнали, что с возможностью вируса Зика
вызывать микроцефалию они «несколько
погорячились».
Статистически эта особенность вируса не
подтверждается
Работы над созданием вакцины – остановлены
Какова была цель этой информационной «утки»
пока не совсем ясна, и не ясно, узнаем ли мы
когда-нибудь правду, или нет …
36. Болезнь, вызванная вирусом Зика
Возбудителя лихорадки Зика уже назваливирусом идиотии
И это определение можно трактовать
по-разному – как с точки зрения
возможной связи с микроцефалией, так и
в связи с неадекватным восприятием
угрозы
37. Роль инфектологии
XIX – XX в.в. ознаменовалисьвпечатляющими победами над многими
массовыми инфекционными болезнями.
Эти достижения привели к формированию
ложного представления об общей победе
человечества над заболеваниями инфекционной
природы и незначительной роли этой патологии в
общей структуре заболеваемости и смертности.
В последнее время значимость инфекционных
болезней в общей структуре заболеваемости не
только не снижается, но и нарастает.
38. Роль инфектологии
Инфекционная патология эволюционируетвместе с развитием всего человечества: возникают
новые аспекты в этой проблеме, новые тенденции в
диагностике, лечении и профилактике инфекционных
заболеваний, расширяется круг заболеваний и
перечень возбудителей.
Практика показала, что только одна инфекция –
натуральная оспа – является условно
ликвидированной.
По данным ВОЗ к началу XXI в. смертность от
инфекционных болезней составляет ¼ часть всех
смертей в мире, а в развивающихся странах –
половину.
39. Роль инфектологии
Ежегодно от инфекционных заболеваний умираетболее 13 млн человек, причем каждый час от инфекций
умирает около 1500, более половины из которых – дети
младше 5 лет.
Самые частые причины смерти – диарея, пневмония,
туберкулез, корь, вирусные гепатиты, малярия и ВИЧинфекция.
Удельный вес летальных исходов инфекционных
болезней в структуре общей смертности населения
определяется социально-экономическими условиями
жизни пациентов и составляет 5% – в Европе, 61% – в
Африке.
В России удельный вес смертности от инфекционных
заболеваний уменьшился с 40% до 1,7%. Он варьирует от
0,3% – в Таймырском АО, до 5,7% – в Республике Тыва.
40. Роль инфектологии
За последние 30 лет было открыто более 35 новыхвозбудителей ранее неизвестных инфекционных болезней:
легионеллез, клещевые боррелиозы, вирусные гепатиты
Е, С, G, TTV, SEN, геморрагические лихорадки Эбола,
Ласса, ВИЧ, Лихорадка Западного Нила, лихорадка Зика.
В 2003 году описана новая антропонозная коронавирусная
инфекция – тяжелый острый респираторный синдром –
ТОРС, атипичная пневмония, 2006 год – птичий грипп
(H5N1), 2009, 2016 годы – свиной грипп (H1N1); 2019 год –
новая коронавирусная инфекция COVID-19
«Возвращающееся» инфекции – дифтерия, холера, брюшной
тиф, чума.
Медленные инфекции, обладающие длительным –
в течении нескольких десятков лет – инкубационным
периодом (Куру, амниотрофический лейкоспонгиоз и др.)
41. Инфекционные болезни -
Инфекционные болезни (от латинского infectio – заражение, загрязнение)группа заболеваний, вызываемых патогенными или
условно-патогенными микроорганизмами,
характеризующаяся заразительностью, наличием
инкубационного периода, циклическим развертыванием
клинических симптомов и формированием
специфического иммунитета.
Отличительный признак – массовость, быстрое
распространение, высокая летальность.
42. Инфекционный процесс
процесс взаимодействия микро- имакроорганизма в условиях влияния
внешней среды
43. Основные формы инфекционного процесса
Носительство- транзиторное
- реконвалесцентное
острое
хроническое
Манифестная форма
Типичная
- острая
- хроническая
Атипичная
- стертая
- латентная
Медленная инфекция
Микст-инфекция
44. Основные формы инфекционного процесса
Инаппарантная форма – отсутствие клиническихпроявлений
Реинфекция – повторное заражение
Суперинфекция – заражение новым агентом на
фоне инфекционного заболевания
Эндогенная инфекция
обострение – повторное ухудшение
рецидив – возврат
осложнения – (специфические, неспецифические)
45. Участники инфекционного процесса
Микроорганизм(патогенный или условнопатогенный) – возбудитель
болезни
Организм хозяина
(человека или животного)
Определенные условия
внешней среды
46.
Определенные условия внешней среды47. Ворота инфекции -
Ворота инфекции место внедрения микроорганизма ворганизм хозяина:
кожные покровы
слизистые оболочки дыхательных путей,
желудочно-кишечного
тракта, половых органов
через кровь
48. Неспецифические факторы защиты макроорганизма
целостность кожных покровов и слизистых оболочек;секреты сальных и потовых желез;
нормальная микрофлора организма;
кислотность желудочного сока;
лизоцим, комплемент, активный фагоцитоз, система
интерферона;
моторика кишечника;
двигательная активность ресничек респираторного
эпителия.
49. Иммунный ответ организма -
Иммунный ответорганизма важнейший механизм защиты макроорганизма от
воздействия возбудителя.
Он включает:
клеточные реакции, связанные с фагоцитами
(гранулоцитами, клетками макрофагальномоноцитарной системы);
гуморальные реакции за счет специфических
антител (Ig M, Ig G) и неспецифических антител
(Ig A, Ig E).
50. Общие особенности инфекционных болезней:
специфический возбудитель;контагиозность (заразность);
склонность к широкому эпидемическому
распространению;
цикличность клинического течения;
формирование иммунных
реакций в организме.
51. Цикличность течения инфекционных болезней
реализуется сменой четко определенных периодовболезни:
Инкубационный (скрытый) период
Продромальный (начальный) период
Период основных проявлений (разгара) болезни
Период угасания симптомов (ранней
реконвалесценции)
Период выздоровления (реконвалесценции)
52. Основные клинические проявления инфекционных болезней:
1. лихорадка2. гепатоспленомегалия
3. лимфоаденопатия
4. экзантемы и энантемы
5. диарея
6. катаральный синдром
7. менингеальный синдром
8. поражение суставов
9. поражение сердечно-сосудистой и
мочевыделительной систем
53. Лихорадки
54. Гепатоспленомегалия
55. Лимфоаденопатия
56. Экзантемы
57. Энантемы
58. Диарея
59. Катаральный синдром
60. Менингеальный синдром
61. Поражение суставов
62. Поражение сердечно-сосудистой и мочевыделительной систем
63. Методы диагностики инфекционных болезней:
- Клинические- Лабораторные
- Инструментальные
64. Клинические методы диагностики:
Сбор жалоб больного;Анамнез инфекционной болезни;
Эпидемиологический анамнез;
Анамнез жизни;
Клинический осмотр больного:
1. оценка общего состояния больного (сохранность
сознания, возбуждение или заторможенность,
наличие психических нарушений, адекватность
поведения и т.д.);
2. последовательное объективное обследование всех
органов и систем.
65. Лабораторные методы диагностики:
1.2.
Общие (неспецифические): общие анализы крови и мочи,
ЭКГ, рентгенографические методы и др.).
Специфические (для подтверждения этиологии болезни,
контроля выздоровления):
А) паразитологические;
микроскопические;
бактериологические;
вирусологические;
Б) обнаружение специфических антител и антигенов:
иммунологические;
серологические;
66. Лабораторные методы диагностики:
В) молекулярно-биологические:ДНК-гибридизация, амплификация, ПЦР
(полимеразная цепная реакция).
Г) кожно-аллергические пробы с микробными
аллергенами.
67. Паразитологические методы
68. Микроскопические методы
69.
70. Бактериологические методы
71. Вирусологические методы
72. Серологические методы
73. Биологические методы
74. Аллергические методы
75. Инструментальные методы диагностики
- ректороманоскопия;- фиброколоноскопия;
- ирригоскопия;
- УЗИ;
- лапароскопия;
- пункционная биопсия;
- ЭКГ, ЭхоКГ
- компьютерная томография.
76. Принципы терапии инфекционных заболеваний
- комплексность воздействия на возбудителяболезни и организм больного:
1. Этиотропная терапия
2. Патогенетическая терапия
3. Симптоматическая терапия
77. Этиотропное лечение
Воздействие на возбудителяХимио- и антибиотикотерапия
Бактериофаготерапия
Воздействие на специфические токсины, связанные
с жизнедеятельностью возбудителей
Специфические антитоксические
сыворотки
Иммуноглобулины
Кристаллоидные и коллоидные
растворы
78. Лечение
Воздействие на реактивность больногоВакцинотерапия
Трансфузии крови и ее препаратов
Иммуноглобулины для внутривенного и
внутримышечного введения
Физиотерапия
Диетотерапия
Режим, диета, гигиенические мероприятия
79. Лечение
Воздействие на отдельные звеньяпатологического процесса
Сердечно-сосудистые препараты
Средства воздействия на нервную систему
Препараты, нормализующие
микрофлору
Ферментные препараты
Лечение осложнений и сопутствующих заболеваний

medicine
medicine








